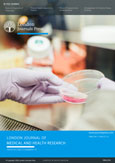
Innovative Scientific Research Lab Modern laboratory with scientists conducting research experiments.

Our Services
Our Publishing
Benchmarks
Print &
e-Journals
Know more about all the journals published with Great Britain Journals Press.
Submit
Research Paper
An international platform to publish original research papers, articles and review papers.
About
GBJP
Our Methodologies, philosophy, model, and work ethics.
Subscribe
Journals
Subscription available for individuals, universities and institutions (print & online).
Hub For Editors
and Reviewers
For Editors
For Reviewers
For Librarians
Researchers
Connected
Countries
Collborating
Awards & honors
Collaborations
& Indexes
Great Britain Journals Press works closely with researchers, academicians, universities, nearly all open access indexing organizations and facilitates them with online platforms and groundbreaking infrastructure that aid their research activities. We provide computation power, research map, cloud infrastructures, analytics solutions, dedicated servers for research analysis, knowledge base and many other pioneer tools to our associates with an emphasis on data integrity for high availability research simulation services.




Capabilities
Transforming
Research
With Technology
Connect
Conferences and
webinars
Browse conferences, seminars, symposiums, and webinars worldwide. Authorities, coordinators, universities can collaborate, associate, or host with us.
Individual books
Reservoir :
Thesis &
Dissertation
Providing a reservoir platform for research studies comprising thesis/dissertation of Ph.D., D.Sc, D.Litt., LL.D. D.M., M.D., M.Phil., M.S. or equivalent. Great Britain Journals Press provides an exclusive platform for researchers to publish thesis and dissertations and publish as individual books. They may also opt-in to submit review books.
Meet The Elites
Research
Community For
Better
Collaborations
GBJP’s Research Community has helped thousands of researchers to collaborate and work on new dimensions of research & science.
Direction
It’s aim is to bring top researchers, scholars and scientists together so that they can share and discuss their work
News & Blogs

.png)









